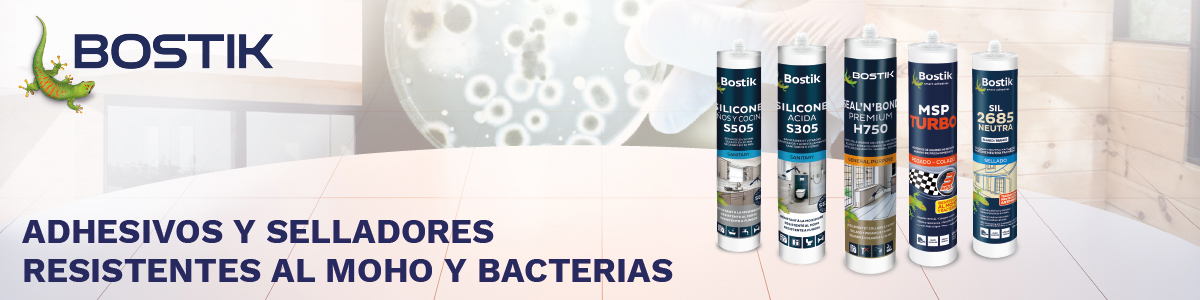
Banner

CATÁLOGO DE PRODUCTOS
Aquí podrás consultar todos los productos de suministros industriales que ofrecemos de forma digital, para que encuentres aquello que buscas rapidamente.
NUESTROS CATÁLOGOS
Descubre los catálogos digitales de Aside
en formato online.
MARCAS DESTACADAS
NOVEDADES
Te mostramos nuestras selección de las últimas novedades en productos de suministro industrial, para que conozcas de primera mano lo más nuevo del mercado.

.jpg)


 Herramienta manual
Herramienta manual Herramienta para taller
Herramienta para taller Herramienta de corte
Herramienta de corte Abrasivos
Abrasivos Soldadura
Soldadura Fijación
Fijación Protección laboral
Protección laboral Equipamiento taller
Equipamiento taller Productos químicos
Productos químicos Medición
Medición


















.jpg)

.jpg)



.jpg)


.jpg)










